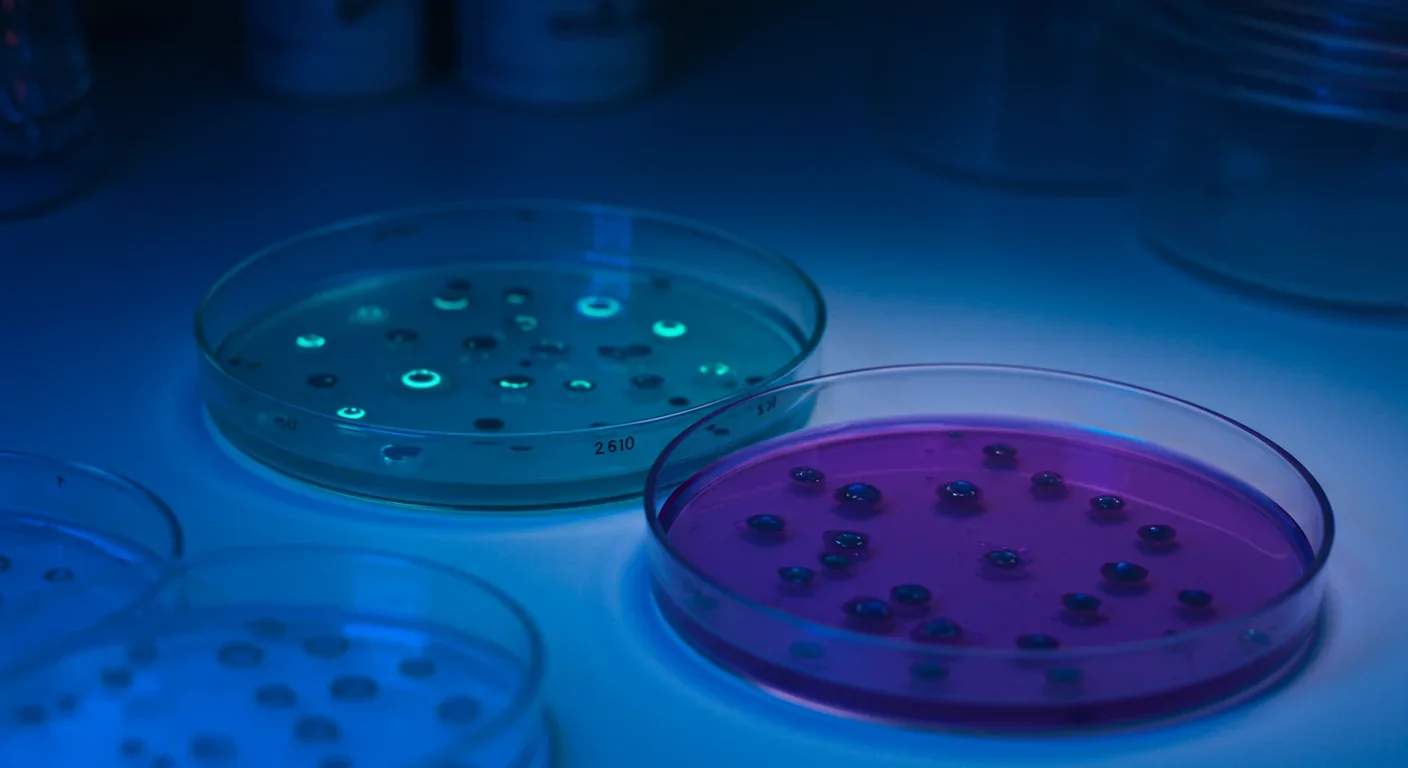
Cell cultures in petri dishes under microscope illumination in research lab

Ancient Archaea in Your Gut: Rewriting Human Biology

TL;DR: Proteostasis collapse—the breakdown of cellular protein quality control systems—connects Alzheimer's, Parkinson's, ALS, and other aging diseases through a common mechanism. New therapeutic strategies targeting chaperones, proteasomes, and autophagy offer hope for prevention and treatment.

Every second, your cells perform millions of delicate molecular origami folds, sculpting chains of amino acids into the precise three-dimensional proteins that keep you alive. When this system works, proteins fold correctly, perform their jobs, then get recycled. When it fails—as it increasingly does with age—the consequences ripple through every aspect of human health.
Scientists call this breakdown proteostasis collapse. It's not just one disease pathway among many. Researchers now recognize it as a fundamental driver connecting Alzheimer's, Parkinson's, ALS, cardiovascular disease, and even cancer. The question facing medicine today isn't whether proteostasis matters, but whether we can fix it before it's too late.
Inside each of your cells operates a sophisticated quality control system that would make any factory manager envious. Molecular chaperones—proteins whose job is to help other proteins fold correctly—patrol constantly, catching mistakes before they compound. The proteasome acts like a cellular shredder, grinding up damaged proteins. Autophagy functions as the recycling department, breaking down not just individual proteins but entire damaged organelles.
This proteostasis network handles an astonishing workload. A typical human cell contains over 100,000 different proteins, with new ones being synthesized and old ones degraded continuously. Between five and 30 percent of newly made proteins misfold on their first attempt. Without intervention, these molecular mistakes would pile up catastrophically within hours.
The system evolved multiple fail-safes. When misfolded proteins accumulate, cells activate the unfolded protein response (UPR), ramping up chaperone production and temporarily slowing new protein synthesis. Heat shock proteins like HSP70 and HSP90 provide emergency rescue for proteins damaged by stress. Chaperone-mediated autophagy offers a targeted disposal method for specific problem proteins.
Yet despite these elaborate safeguards, the system has an Achilles' heel: it deteriorates with age.
Between five and 30 percent of newly made proteins misfold on their first attempt. Without the cell's quality control systems, these mistakes would pile up catastrophically within hours.

The decline isn't subtle. Studies show that HSP70 levels in cerebrospinal fluid drop significantly with aging, correlating with increased oxidative stress. The proteasome's ability to degrade proteins decreases by 30-50 percent in aged tissues. Autophagy becomes sluggish, with aged cells showing reduced formation of autophagosomes—the membrane-bound structures that engulf cellular debris.
The reasons behind this collapse involve a toxic feedback loop. As proteostasis machinery degrades, more proteins misfold. These misfolded proteins can themselves damage the very systems meant to clear them. Research demonstrates that certain ubiquitin-conjugating enzymes essential for marking proteins for degradation become less active, creating a cascading failure.
Environmental factors accelerate the process. Oxidative stress modifies proteins, making them harder to fold correctly. Inflammation interferes with chaperone function. Even exposure to chronic heat stress has been shown to age you as much as smoking, likely through overwhelming proteostasis capacity.
At the molecular level, the crisis manifests through protein aggregation. Unable to maintain proper structure, proteins clump together into insoluble aggregates that become progressively more resistant to clearance. These aggregates aren't just cellular garbage—they're toxic, interfering with normal cellular functions and often seeding the formation of even more aggregates.
The connection between proteostasis collapse and specific diseases reveals a pattern that was hiding in plain sight. Each neurodegenerative disease features a signature protein that goes wrong: amyloid-beta and tau in Alzheimer's disease, alpha-synuclein in Parkinson's, SOD1 and TDP-43 in ALS. These aren't random different diseases—they're variations on the same theme of failed protein quality control.
In Alzheimer's, tau protein normally stabilizes the internal scaffolding of neurons. When proteostasis fails, tau becomes hyperphosphorylated and misfolds, forming neurofibrillary tangles that strangle neurons from within. Amyloid-beta peptides, which should be cleared routinely, instead accumulate into plaques that trigger inflammation and further stress the proteostasis network.
Parkinson's disease follows a similar trajectory with alpha-synuclein. This protein typically helps regulate neurotransmitter release. Misfolded versions cluster into Lewy bodies that kill dopamine-producing neurons, causing the characteristic motor symptoms. Recent landmark studies have even managed to halt this toxic protein's spread in experimental models.
"Proteostasis collapse is a central driver of aging and age-related neurodegenerative diseases, including Alzheimer's, Parkinson's, and ALS."
— MDPI Applied Sciences Review Article
ALS presents perhaps the most devastating example. Motor neurons, which have exceptionally high protein production demands, become overwhelmed when quality control falters. Aggregates of SOD1, TDP-43, or FUS proteins accumulate, progressively stripping away the ability to move while leaving cognition intact.
But proteostasis failure extends beyond the brain. Age-related cataracts result from crystallin protein aggregation in the eye lens. Cardiovascular disease involves misfolded proteins accumulating in blood vessel walls. Cancer cells often hijack proteostasis machinery, using enhanced chaperone activity to survive stress that would kill normal cells.
The common thread: when protein quality control breaks down, the consequences depend on which cell types fail first and which proteins they depend on most heavily.
Understanding how proteostasis collapses requires examining its three main pillars: chaperone systems, the proteasome, and autophagy.
Molecular chaperones function like cellular coaches, guiding proteins through the folding process. The HSP70 family catches newly synthesized proteins, preventing aggregation while they fold. HSP90 stabilizes proteins in their final configurations. Small heat shock proteins act as first responders, binding misfolded proteins to prevent them from clumping while waiting for more powerful chaperones to arrive.
With age, chaperone production drops while demand increases—a catastrophic mismatch. The heat shock response, which should ramp up chaperone production under stress, becomes less sensitive. Aged cells require higher stress levels to trigger the same protective response, leaving them vulnerable to protein damage.
The ubiquitin-proteasome system provides targeted protein destruction. Proteins destined for degradation get tagged with chains of ubiquitin molecules—like putting a "demolish this" sign on a building. The proteasome, a barrel-shaped complex, recognizes these tags and threads the protein through its central channel, chopping it into small peptides for recycling.
This system's decline with aging proves especially problematic because the proteasome itself contains numerous precisely folded proteins that must work together. When proteasome components themselves become damaged, the entire degradation apparatus slows, creating a vicious cycle.
Autophagy—literally "self-eating"—handles larger-scale cleanup. When specific proteins or entire organelles need removal, the cell encases them in a double-membrane vesicle called an autophagosome, which then fuses with a lysosome for degradation. Chaperone-mediated autophagy provides an even more selective pathway, with chaperones directly delivering problem proteins to lysosomes.
All forms of autophagy decline with age. Lysosomal function deteriorates, autophagosome formation slows, and the cellular sensors that should trigger autophagy under stress become less responsive.
The proteasome's ability to degrade proteins decreases by 30-50 percent in aged tissues, creating a catastrophic mismatch between damage and repair capacity.
Cells didn't evolve to accept protein misfolding quietly. When misfolded proteins accumulate in the endoplasmic reticulum—the cellular factory where many proteins get made—it triggers a sophisticated alarm system called the unfolded protein response.
The UPR operates through three sensor proteins embedded in the ER membrane. When they detect problems, they initiate a coordinated response: temporarily halt new protein production, increase chaperone synthesis, enhance degradation pathways, and expand ER capacity. If stress persists despite these interventions, the UPR switches to promoting cell death—better to sacrifice one damaged cell than risk contaminating neighbors.
This emergency system generally works well in young, healthy cells. But with aging, the UPR itself becomes dysregulated. In some contexts, it activates too easily, causing unnecessary cell death. In others, it remains chronically active at low levels, creating persistent inflammation without fully resolving the protein stress.
Recent research reveals how aging fundamentally alters UPR signaling. Aged muscle tissue shows a blunted UPR after exercise compared to young muscle, limiting the beneficial adaptations that exercise normally provides. Meanwhile, aging-related tumors exploit chronic ER stress to fuel their aggressiveness, using the UPR to survive in hostile environments.
The UPR's failure represents a particularly concerning aspect of proteostasis collapse because it's meant to be the safety net when primary quality control systems fail.

The proteostasis crisis has sparked a race to develop interventions, with approaches ranging from drugs that boost chaperone activity to compounds that enhance protein clearance.
Pharmacological chaperones represent one promising avenue. These small molecules work by stabilizing proteins in their correct conformation, preventing misfolding in the first place. Unlike traditional chaperone proteins, they can cross cell membranes and even the blood-brain barrier. A recent study demonstrated that a single chaperone stabilizer could rescue the expression and function of the vast majority of pathogenic variants in a critical receptor protein.
Heat shock protein activators aim to boost the cell's endogenous quality control machinery. Compounds that activate HSF1—the master regulator of heat shock protein production—have extended lifespan in animal models. The challenge lies in activating heat shock responses specifically where needed without causing system-wide stress.
Autophagy enhancers have shown remarkable promise. Rapamycin, which activates autophagy by inhibiting the mTOR pathway, extends lifespan in every organism tested, from yeast to mice. The compound trehalose induces autophagy through a different mechanism and has shown benefits in models of neurodegeneration. Spermidine, a natural compound found in foods like wheat germ and soybeans, promotes autophagy and correlates with extended lifespan in population studies.
Proteasome activators present technical challenges since the proteasome is already a large, complex machine. However, researchers have identified compounds that enhance its activity, and maintaining levels of key ubiquitin-conjugating enzymes like UBE2D appears to preserve proteasome function during aging.
Combination approaches may prove most effective. Preliminary evidence suggests that pairing small-molecule chaperone modulators with immunotherapy targeting protein aggregates—like the antibodies being developed for Alzheimer's—shows synergistic effects in clearing plaques.
"Pharmacological activation of the heat-shock response and enhancement of autophagy extend lifespan in C. elegans and mouse models."
— MDPI Applied Sciences Review Article
While many proteostasis-enhancing drugs remain in development, several interventions supported by current evidence may help maintain protein quality control.
Exercise stands out as a powerful proteostasis booster. Physical activity induces temporary stress that activates heat shock responses and autophagy. Studies show that exercise increases HSP60 expression and reduces inflammation in diabetic and obese individuals. The key appears to be regular but not excessive stress—chronic overtraining can overwhelm proteostasis capacity.
Dietary approaches show promise. Intermittent fasting and caloric restriction enhance autophagy, possibly explaining their lifespan-extending effects in animal studies. Foods rich in autophagy-promoting compounds—including green tea, coffee, turmeric, and cruciferous vegetables—may provide modest benefits.
Heat exposure through sauna use has gained attention for its ability to induce heat shock proteins. While chronic heat stress is harmful, brief controlled exposures may train proteostasis systems. Regular sauna users show reduced risks of neurodegenerative disease in population studies, though whether heat shock protein induction explains this remains unproven.
Avoiding chronic inflammation and oxidative stress matters. These states continuously damage proteins, overwhelming quality control systems. Managing chronic diseases, maintaining healthy sleep, and reducing exposure to environmental toxins all reduce the proteostasis burden.
Supplements that may support proteostasis include spermidine, which naturally declines with age, and urolithin A, a compound that enhances mitophagy—the specific autophagy of damaged mitochondria. Both show preliminary evidence in human trials, though optimal dosing remains uncertain.

The convergence of aging biology, proteomics, and drug development has created unprecedented opportunities to address proteostasis collapse. Multiple clinical trials are now testing proteostasis-targeting interventions in humans.
Key questions remain. Why do specific proteins aggregate in specific diseases? Can we predict which individuals will experience proteostasis failure earliest? What's the optimal age to begin intervention—before problems emerge, or only when symptoms appear?
The challenge of measuring proteostasis in living humans complicates clinical development. Unlike cholesterol or blood pressure, we lack simple biomarkers for protein quality control capacity. Researchers are developing assays that could assess proteostasis status through blood samples, potentially enabling early intervention and monitoring treatment response.
Combination therapies targeting multiple aspects of proteostasis simultaneously may prove essential. Just as cardiovascular disease requires managing multiple risk factors, restoring proteostasis likely demands enhancing chaperones, clearing aggregates, and promoting degradation pathways together.
The field has also recognized that different tissues and cell types have distinct proteostasis vulnerabilities. Motor neurons in ALS have different requirements than dopamine neurons in Parkinson's. Personalized proteostasis medicine may need to target interventions based on individual protein expression patterns and disease risks.
Looking further ahead, gene therapy approaches could restore proteostasis capacity more durably than small molecules. Delivering genes encoding key chaperones or autophagy components directly to vulnerable cells could provide long-term protection. CRISPR-based approaches might even correct the underlying genetic variants that predispose to protein misfolding diseases.
Multiple clinical trials are now testing proteostasis-targeting interventions in humans, with results expected within the next five years that could reshape how we approach aging diseases.
The recognition of proteostasis collapse as a central aging mechanism represents more than identifying another disease pathway. It suggests that diverse age-related conditions—previously thought to be separate diseases requiring separate treatments—may stem from a common root cause.
This has profound implications. Rather than developing a drug for Alzheimer's, another for Parkinson's, and yet another for ALS, we might develop interventions that prevent or reverse the proteostasis decline underlying all of them. The first person to benefit from such treatments might not even have symptoms yet, maintaining protein quality control capacity throughout life to prevent these diseases from ever emerging.
The proteostasis field also illustrates how aging research has matured from observing decline to engineering intervention. We're no longer just cataloging what goes wrong. We're identifying specific molecular failures and developing precise tools to fix them.
The diversity of diseases linked to proteostasis—from neurodegeneration to cancer to metabolic dysfunction—means that successfully restoring protein quality control could be one of the highest-leverage interventions in medicine. A therapy that keeps proteostasis working properly wouldn't just treat one disease but potentially prevent dozens.
We're witnessing a shift from asking "how do we cure Alzheimer's?" to "how do we maintain cellular quality control?" That question reaches much deeper into the mechanisms of aging itself. The answer could reshape not just how long we live, but how well we live—keeping the molecular machinery that defines us running smoothly from youth into our final years.
The race is on to translate these insights from laboratory models to human therapies. Given the pace of research and the number of promising approaches in development, the next decade should reveal whether proteostasis enhancement can deliver on its remarkable potential. For millions living with or at risk for protein misfolding diseases, the possibility that cellular quality control could be restored—rather than simply slowed in its decline—offers something increasingly rare in modern medicine: genuine hope for prevention, not just treatment.

Lunar mass drivers—electromagnetic catapults that launch cargo from the Moon without fuel—could slash space transportation costs from thousands to under $100 per kilogram. This technology would enable affordable space construction, fuel depots, and deep space missions using lunar materials, potentially operational by the 2040s.

Ancient microorganisms called archaea inhabit your gut and perform unique metabolic functions that bacteria cannot, including methane production that enhances nutrient extraction. These primordial partners may influence longevity and offer new therapeutic targets.

CAES stores excess renewable energy by compressing air in underground caverns, then releases it through turbines during peak demand. New advanced adiabatic systems achieve 70%+ efficiency, making this decades-old technology suddenly competitive for long-duration grid storage.

Human children evolved to be raised by multiple caregivers—grandparents, siblings, and community members—not just two parents. Research shows alloparenting reduces parental burnout, improves child development, and is the biological norm across cultures.

Soft corals have weaponized their symbiotic algae to produce potent chemical defenses, creating compounds with revolutionary pharmaceutical potential while reshaping our understanding of marine ecosystems facing climate change.

Generation Z is the first cohort to come of age amid a polycrisis - interconnected global failures spanning climate, economy, democracy, and health. This cascading reality is fundamentally reshaping how young people think, plan their lives, and organize for change.

Zero-trust security eliminates implicit network trust by requiring continuous verification of every access request. Organizations are rapidly adopting this architecture to address cloud computing, remote work, and sophisticated threats that rendered perimeter defenses obsolete.